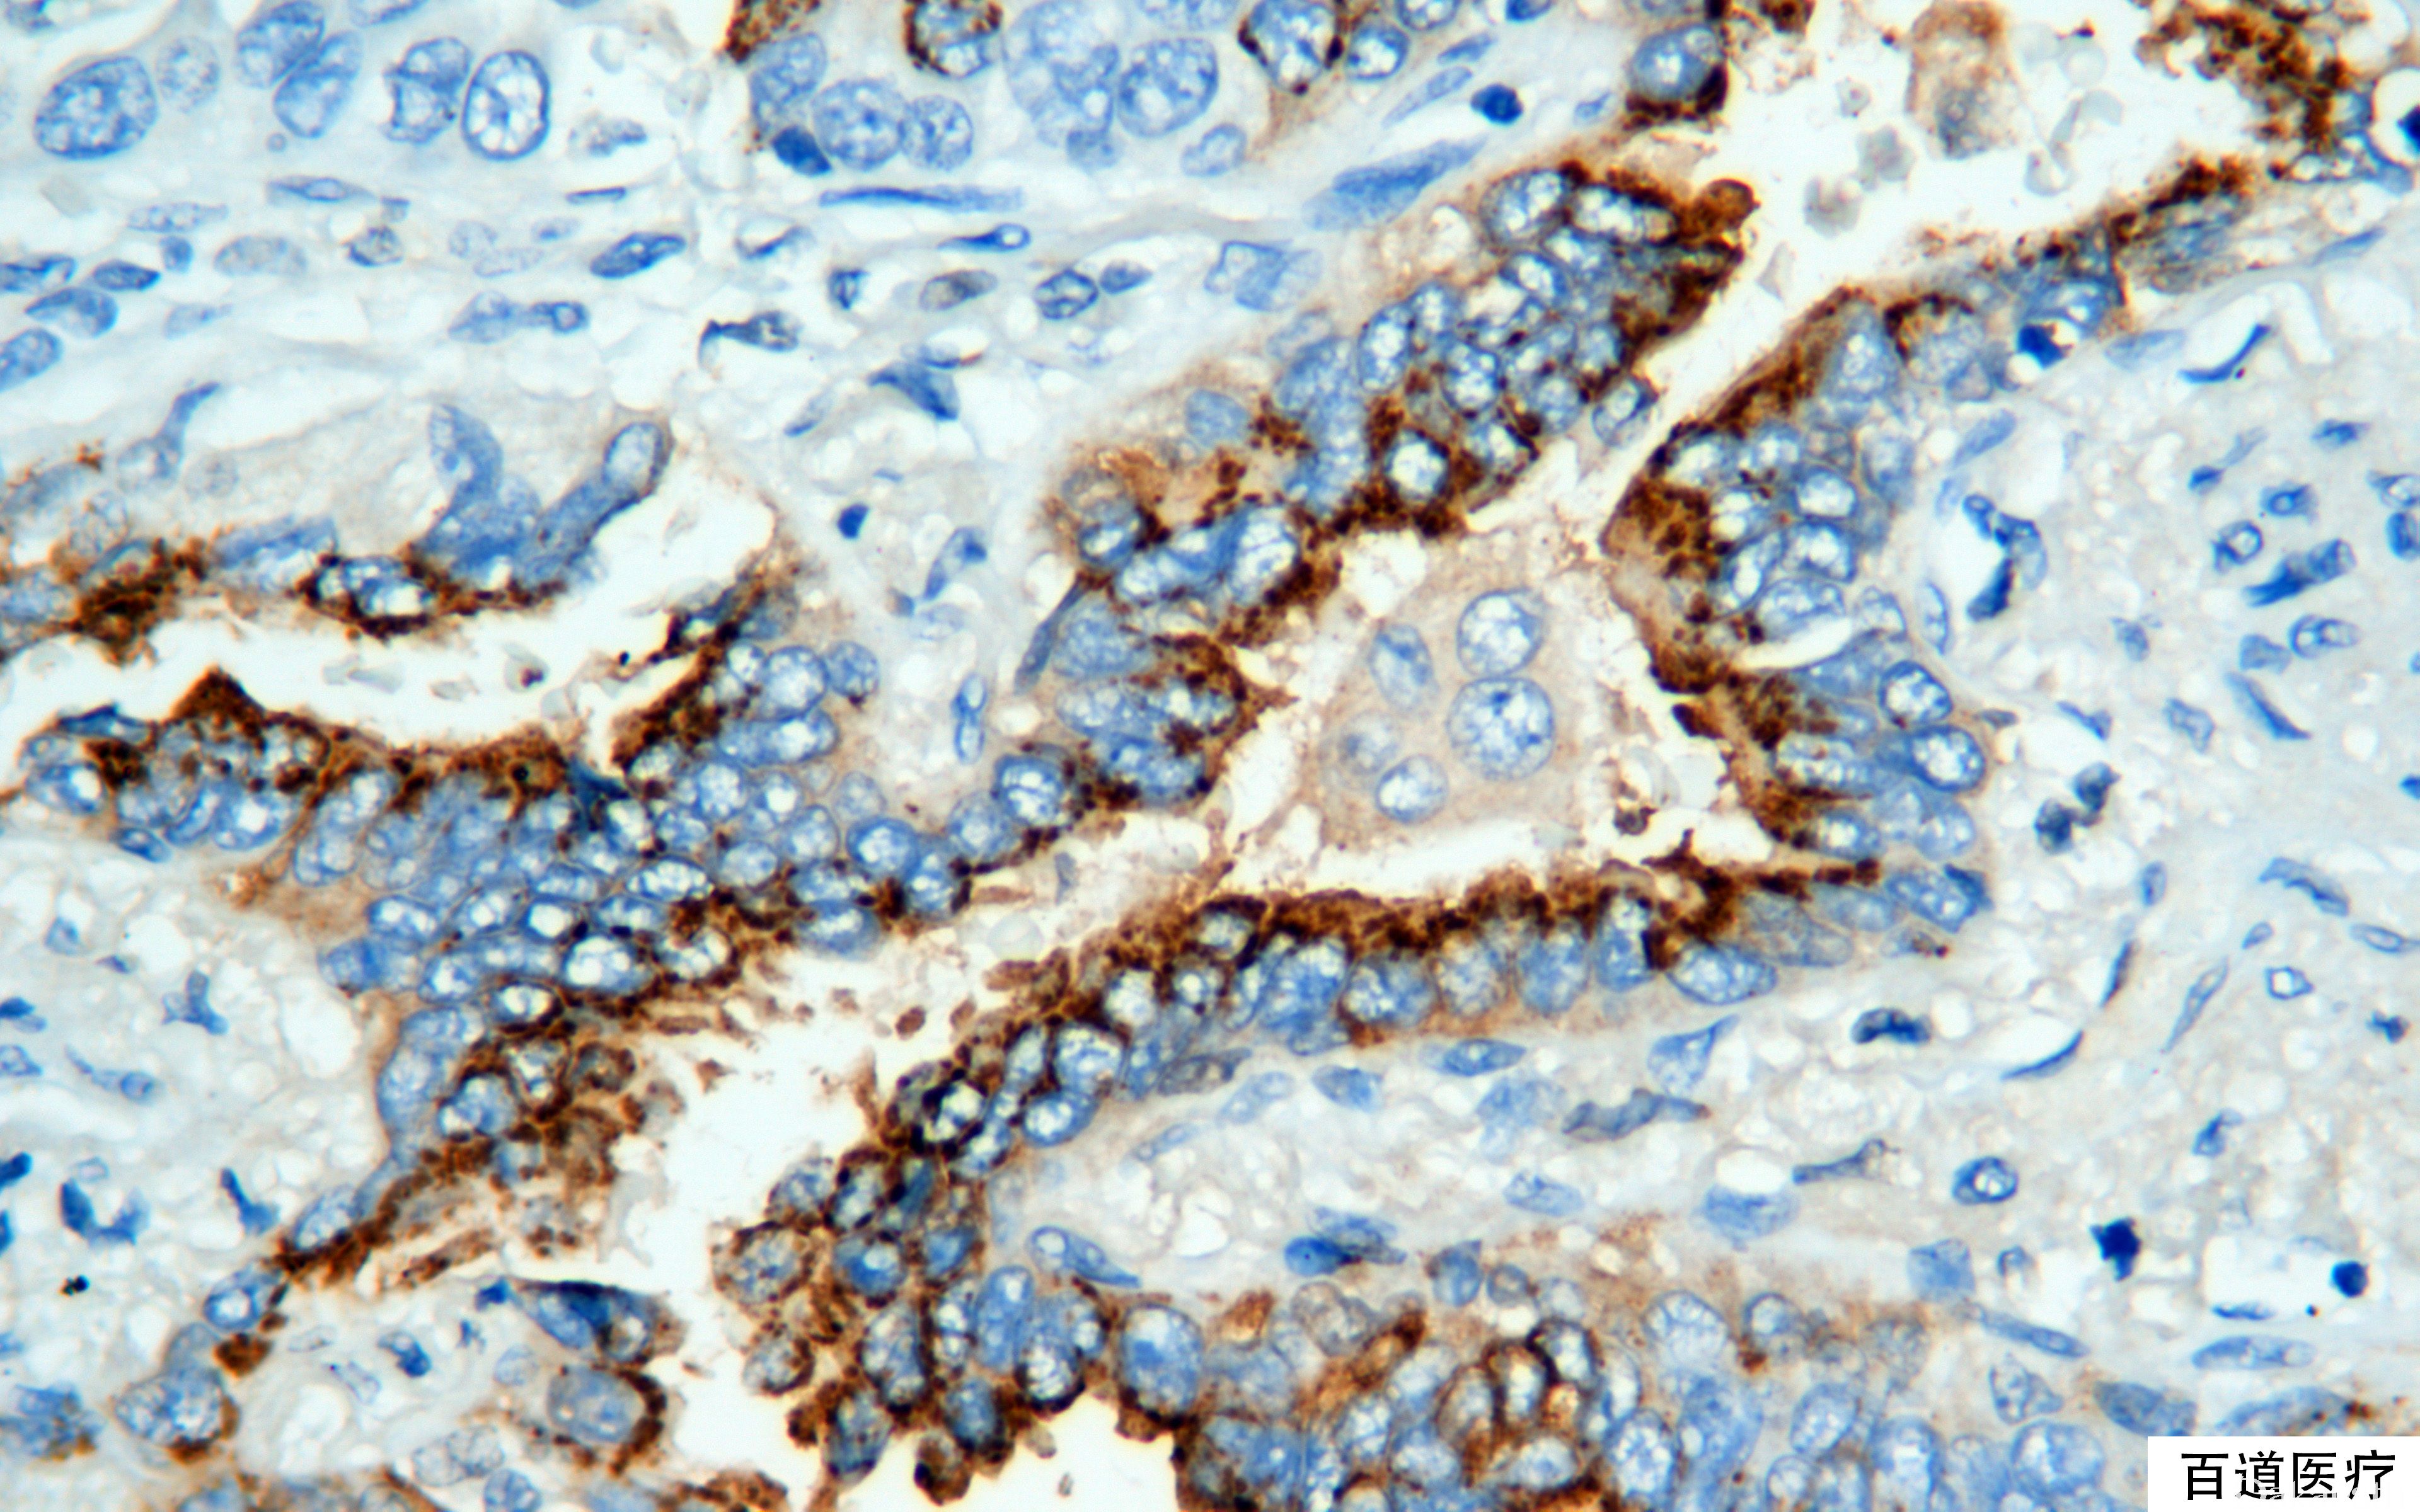

COX-2
别名: 环氧化物酶 2
概述:
在细胞凋亡和肿瘤发生中起一定作用,在大肠癌和乳腺癌中高表达。
信号定位: 胞质、胞膜
在病理学中的应用:
大肠癌和乳腺癌中高表达;
食管腺癌、肾细胞癌常阳性;
商品化试剂(排名不分先后,本网站对抗体质量不负责!)
公司 | 克隆号 | 即用型(ml) | 原液(ml) | ||||
基因科技 | SP21 | / | 2 | 4 | 7 | / | 0.2 |
赛诺特 | 4H12 | 1 | 3 | 6 | / | 0.1 | 0.2 |
SP21 | |||||||
中杉金桥 | SP21 | 1.5 | 3 | 6 | / | 0.1 | 0.2 |
安必平 | SP21 | 1.5 | 3 | 6 | / | 0.1 | 0.2 |
在肿瘤中的表达情况:
几乎全部阳性(≥95%的病例阳性): 角化性囊性牙源性肿瘤,上皮、肾细胞癌、髓母细胞瘤,NOS、原始神经外胚层瘤、肺大细胞癌、深部韧带样纤维瘤病、食管腺癌、骨母细胞瘤
通常阳性(<95%,≥75%的病例阳性): 皮肤鳞状细胞癌、结直肠腺癌、肝细胞癌、甲状腺髓样癌、乳腺导管原位癌、胃肠道间质瘤、恶性嗜铬细胞瘤、乳腺浸润性癌,非特殊类型、甲状腺未分化癌、胰腺导管腺癌
经常阳性(<75%,≥55%的病例阳性): 耳鼻喉鳞状细胞癌、肺鳞状细胞癌、脊索瘤、甲状腺腺瘤、胰胆管腺癌、胃腺癌、前列腺癌,≥gleason8 分、肺腺癌
有时阳性(<55%,≥35%的病例阳性): 甲状腺滤泡性癌、甲状腺乳头状癌
少数阳性(<35%,≥15%的病例阳性): 甲状腺滤泡性腺瘤、嗜铬细胞瘤、室管膜下巨细胞星形细胞瘤、前列腺癌,≤gleason 7、多形性腺瘤、角化棘皮瘤
几乎全部阴性(<5%的病例阳性): 软骨样脊索瘤、腺性膀胱炎